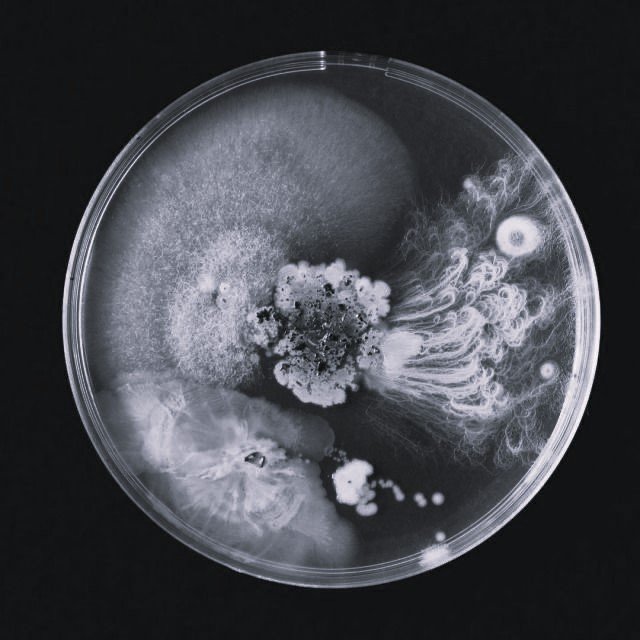

— 01
Longevity Only
Kako izgleda savremeni pristup dugovečnosti?
Savremeni pristup dugovečnosti oblikuje se kroz promišljene izbore koji se oslanjaju na znanje i teže dugoročnom očuvanju ravnoteže tela i duha.

Smart supplementation
Manje, ali smisleno. To je suština pametne suplementacije.


MIKROBIOTA & METABOLIZAM
Briga o mikrobioti je ulaganje u dugoročni metabolički balans.
Estetika dugovečnosti
Estetika dugovečnosti neguje ono što je suštinsko: strukturu, funkciju i prirodan izraz, kroz vreme.
